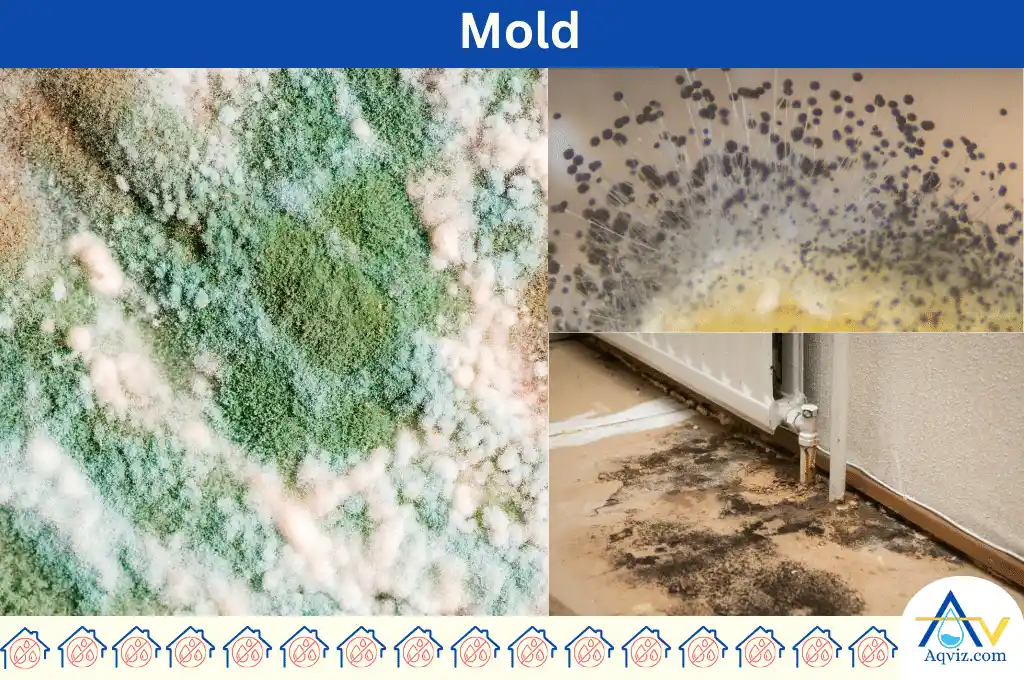
Types of mold in the basement

Basement Mold: Types, Identify, Reasons, Problems, and Elimination
Basement mold is a fungus that grows in multicellular filaments, forming colonies in the basement walls, floors, drywall, and cellar. Molds grow in the basement on organic matter, such as wood, paper, and fabrics. Basement mold grows well at temperatures between 77°F and 86°F (25°C and 30°C) and moisture levels above 60%.
In the basement mold can be found mainly of 6 types according to their colors, such as black, white, yellow, blue, green, and grey. These types are grown at various temperatures and surfaces in the basement.
You can identify the molds in the basement by the musty and earthy smell of the basement, stain marks on the basement wall and floor, allergy symptoms in the basement, using mild test kits in the basement, and peeling paint in the basement. Mold negatively affects on the basement by damaging structures, spending a higher cost on maintenance, decreasing the property values, creating an unpleasant smell in the basement, and increasing the health risk.
You can clean the mold in the basement by following these 5 methods: vinegar spray, baking soda, borax, and bleach. Each of these methods requires specific tools and instruments. When you follow the proper guidelines, you can clean the mold in the basement properly.
Basement mold does not die on its own. Hence, you should prevent mold growth in the basement by waterproofing the basement, installing a dehumidifier, improving the basement ventilation, installing a French drain system, and installing a sump pump in the basement.
What is Mold in the Basement?
The mold in the basement is a multicellular fungus colony that thrives on organic materials like wood, paper, drywall, and insulation in the basement. Mold grows in the basement due to higher humidity, lower sunlight, less air circulation, poor ventilation, and continuous water intrusion conditions in the basement.
The most favourable temperature conditions for mold growth are between 77°F and 86°F (25°C and 30°C). Mold requires moisture levels above 60% and high humidity levels. Basement mold can damage the organic material in the basement. It can produce a stale and earthy smell over time. This smell is harmful and causes respiratory issues in humans. Basement molds are mainly of 6 types of colors, including black, white, yellow, blue, green, and grey.
What are the 6 Types of Mold in the Basement?
Basement molds are mainly of 6 types. Those are identified by the color: black, white, yellow, blue, green, and grey. Each of these molds types are grown on different surfaces at various temperatures in the basement.
- Black molds: Black mold in the basement is also known as Stachybotrys chartarum . Black molds grow in places that are warm and damp. The best temperatures for black mold growth are between 70 and 90℉. Black molds can spread on surfaces like walls, wood, and carpets by damaging those parts.
- White molds: White mold in the basement is scientifically known as Sclerotinia sclerotiorum . White mold prefers cooler temperatures ranging from 40 to 70℉. White mold can spread quickly and damage wood, drywall, insulation, fabrics, and cardboard boxes.
- Yellow Mold: Yellow mold in the basement is known explicitly as Aspergillus . The best temperature conditions for yellow mold are between 60 to 86℉. Yellow mold can damage wood, drywall, carpeting, and insulation in the basement.
- Blue Mold: Blue mold in the basement is scientifically known as Penicillium . Blue mold grows in moderate temperatures ranging from 60 to 70℉. Blue mold can damage basement parts such as wood, drywall, paper, and fabric.
- Green Mold: Green mold in the basement is scientifically known as Aspergillus flavus or Penicillium digitatum. Green mold prefers temperatures between 65 to 75 ℉. Green mold can damage parts of the basement, such as wood, drywall, paper, cardboard, and fabric.
- Grey Mold: Grey mold in the basement is scientifically known as Botrytis cinerea . The optimum temperature for grey mold is between 50 to 70℉. Grey mold can damage materials in the basement, such as cardboard, paper, fabrics, and stored fruits and vegetables.
Related: All About Mold and Mildews: Signs, Causes, Impacts, Elimination

How to Identify Mold in the Basement?
Basement mold can be identified by these 5 ways such as a musty and earthy smell, stain marks on the basement wall and floor, allergy symptoms, using mold test kits, and peeling paint in the basement.
- Musty and earthy smell in the basement: Mold emits a musty smell in the basement similar to wet socks or rotting wood. To detect mold using this scent, first identify when the odor is more significant, such as after rain. Then, check areas with a high possibility, such as carpets, corners of doors, sinks, and pipelines.
- Stain marks on the basement wall and floor: Mold makes dark and grey color stains ranging from green to black-brown on the surfaces. Greenish-black stains indicate household molds like Cladosporium, while brownish stains indicate harmful molds like Stachybotrys chartarum (black mold).
- Allergy symptoms in the basement: The most common symptoms of mold allergies are sneezing, coughing, and eye and skin irritation. If occupants experience these symptoms when spending time in the basement, it indicates the presence of mold.
- Using mold test kits in the basement: The most appropriate mold test kits are a settled plate kit, a tape lift kit, and a swab kit. These test kits collect samples of mold to petri dishes and allow them to grow. The collected samples can be sent to a laboratory to identify the presence of mold.
- Basement wall paint peeling: Basement wall paint peeling or bubbles as moisture occur due to the growth of mold behind the paint. To detect mold, check areas with high humidity. Inspect behind the wall painting for dark spots, decoloration marks, and stains using a flashlight.
What are the 5 Reasons for Basement Mold?
Basement mold can be triggered due to these 6 reasons: higher humidity, lower sunlight, poor ventilation, poor air circulation, water dampness, and rich of organic materials in the basement.
- Higher humidity in the basement: Mold thrives rapidly in the basement when its humidity levels increase to 60%. Basements typically have higher moisture due to proximity to the soil, poor insulation, and occasional water leaks. This causes the production of higher moisture, and it tends to activate and grow on wood, drywall, or stored fabrics.
- Lower sunlight in the basement: The lower sunlight condition in the basement blocks the natural UV light and increases the mold growth over time.
- Poor ventilation in the basement: Poor ventilation prevents the moisture from escaping from the basement. This causes to trapping air and increases the mold growth in the basement.
- Poor air circulation in the basement: Poor air circulation keeps the moisture from evaporating from the basement. It increases the condensation and makes a damped area to stay wet for longer periods, which causes mold to grow in the basement’s organic materials.
- Water dampness in the basement: Continuous dampness from groundwater seepage, leaking pipes, or improper drainage saturates materials like concrete, wood, or insulation, causing them to produce moisture continuously. Once these materials absorb water, mold quickly develops and spreads across nearby surfaces.
- Organic materials in the basement: Organic materials like wood, paper, dry walls, furniture, and clothes are the most common areas for mold growth in the basement. Rich organic materials always make a better surface for the mold under all the above environmental conditions.
What are the Problems of Basement Mold?
These are the 5 most negative effects of basement mold.
- Damages to the basement structure: Mold grows and breaks down in the materials in the basement, degrading the structural integrity. Degradation can deteriorate the materials and increase the rot, causing structural instability.
- Spend higher cost for mold treatment: To remove mold without damaging the basement, users have to consult a professional, and these consultation fees and mold treatments are highly expensive. The high cost of the treatments can put users under financial strain and make them stressed.
- Decrease the property value: Property value can be decreased due to deterioration of materials as a result of paint peeling, bubbling and cracking. These structural damages will reduce the value of the basement, make users unsatisfied, and cause safety issues.
- Unpleasant smell in the basement: Mold can emit a musty and earthy smell that spreads inside the basement and reduces the air quality. The musty odour can cause respiratory issues, allergies, and disturbances for users who are unable to utilize the basement.
- Higher health risk: Excessive exposure to mold and mycotoxins can cause health problems such as skin rashes and irritations, respiratory problems, headaches, and difficulty in concentrating.

How to Eliminate Basement Mold?
You can eliminate basement mold by using hydrogen peroxide, vinegar spray, baking soda, borax, and bleach. And also, if you need to remove it professionally, you can hire a mold cleaning service, and it will cost thousands of US dollars.
To know more about these 5 cleaning methods, you should read more about how to remove basement mold in 5 ways.
1. Clean the Basement Mold Using Hydrogen Peroxide.
First, ensure proper ventilation by opening windows or using fans. Then, mix equal parts of hydrogen peroxide and water in a spray bottle. Spray the moldy areas with the solution and wait 10-15 minutes. Scrub the area using a brush or sponge to remove the mold stains and residue. Rinse the area with clean water and dry it thoroughly. For heavy mold, repeat the process. Finally, dispose of any contaminated materials properly.

2. Clean Basement Mold Using Vinegar Spray
First, mix equal parts of white vinegar and water in a spray bottle. Shake well to combine. Then, spray the vinegar solution directly onto the moldy areas to kill the mold. Let it stay for about an hour to kill the mold. After that, scrub the area with a brush or sponge to remove the mold stains. Rinse the area with water and dry it thoroughly using a clean cloth or towel.

3. Clean Basement Mold Using Baking Soda
Mix one tablespoon baking soda with a cup of water in a spray bottle. Shake it well to dissolve the baking soda. Then, spray the moldy areas with the solution. Let it stay for about 10-15 minutes. After that, scrub the area with a brush or sponge to remove the mold stains. Rinse the area with clean water and dry it thoroughly.

4. Clean Basement Mold Using Borax
First, mix one cup of Borax with one gallon of water. Use a scrub brush or sponge to apply the Borax solution to the moldy areas. Scrub the moldy spots well to remove the mold. Let the Borax solution stay on the surface for about 10 minutes. Then, rinse the area with clean water and dry it thoroughly.

5. Clean Basement Mold Using Bleach
First, open windows for ventilation. Mix one cup of bleach with one gallon of water in a bucket. Dip a brush or sponge into the bleach solution and scrub the moldy areas. Let the bleach stay on the surface for about 15 minutes. Rinse the area with clean water and dry it thoroughly.

How to Prevent Mold Growth in the Basement?
You can prevent mold growth in the basement by waterproofing the basement, installing a dehumidifier, improving the basement ventilation, installing a French drain system, and installing a sump pump system in the basement.
- Waterproof the basement: Basement waterproofing can stop the mold growth and reduce the moisture in the basement. Basement waterproofing regulates the temperature, humidity, and moisture levels to keep it dry. You can waterproof the basement by sealing cracks, installing sump pumps, installing vapor barriers, and installing interior drainage systems.
- Install a dehumidifier in the basement: A Dehumidifier helps to prevent mold growth in the basement. A dehumidifier can absorb the excess moisture and regulate the optimum moisture conditions (around 40%) inside the basement.
- Improve the basement ventilation: Improving the basement ventilation helps reduce mold growth. It can remove the excess moisture in the basement, which is a growth factor for the basement mold. To improve the basement ventilation, you can install new windows, add new vents, and open doors and windows. These will allow fresh air to circulate while maintaining low humidity levels.
- Install a French drain in the basement: A French drain can collect and redirect the excess rainwater away from the foundation. This will dry the basement area by maintaining optimum temperature and low humidity levels, which are less favourable for mold growth.
- Install a Sump Pump in the basement: A sump pump removes excess water that collects in the basement from rain or groundwater. The sump pump can prevent stagnant water formation, keep the basement dry, and decrease the humidity level inside. These conditions are less favorable for mold growth.
To address the basement mold permanently, you should waterproof the basement using proper waterproofing membranes.
Read More About
- How to Waterproof the Basement? Interior, Exterior, and Drainage
- How to Install a Sump Pump?
- How to Install a French Drain?
Can Mold Growth Die on Its Own?
Mold can become inactive and hibernate in unfavorable conditions, but it cannot die on its own. Mold spores can survive in harsh conditions and wait for favorable conditions. Extreme temperature conditions, both hot and cold, low humidity levels, and high ventilation can reduce mold growth, but they can hibernate until the conditions are favorable for them. Therefore, to eradicate mold, we should use a proper mold removal method.